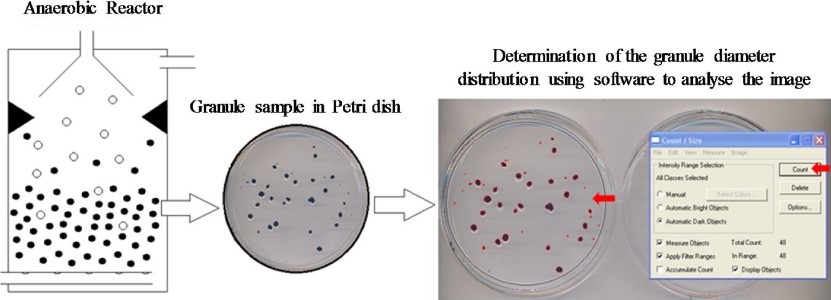
Fig.1 Determination process of biological sludge particle diameter distribution. (Alves, et al., 2018)

Sludge Granule Size Analysis Service
Comprehensive Sludge Particle Size Analysis Services at Creative Biolabs
Anaerobic digestion is a biological treatment process that uses anaerobic bacteria to decompose organic waste under anaerobic conditions to produce biogas and organic fertilizers. In this process, size analysis of sludge particles is very important. Because particle size will directly affect the attachment and growth of microorganisms, larger particles may be more difficult to degrade by microorganisms, thus affecting digestion efficiency. Creative Biolabs has advanced analysis equipment, and we provide a series of Anaerobic Digestion-related services, such as Biomethane Potential Analysis, Organic Matter Analysis, Sludge Activity Analysis, Anaerobic Toxicity Analysis, and sludge granule size analysis services. Analyzing sludge granule size in anaerobic digestion helps optimize the treatment process, control sludge concentration, monitor treatment effectiveness, and ultimately improve gas production and system operating efficiency.
The steps involved in analyzing sludge granule size during anaerobic digestion include the following key stages:
Sample collection
The analysis samples provided by the client need to ensure that they are representative samples from the entire anaerobic digestion system.
Sample processing
After we receive the sample, we will perform pre-processing steps such as dilution and stirring to ensure that the particles in the sample are evenly distributed and avoid aggregation affecting subsequent analysis results.
Determination of samples
We choose the most suitable method to analyze sludge granule size according to the client's needs and actual conditions.
We place the sample on a glass slide and directly observe and record the shape and size of the sludge particles by adjusting the magnification of the microscope. This method provides high-resolution images, and then we determine the particle size by measuring parameters such as the diameter and area of the particles.
-
Laser particle size analysis
We transfer the sample to a laser particle size analyzer to quickly and accurately measure the size distribution of the sludge particles using laser scattering technology.
-
Dynamic light scattering analysis
This is a technology based on the principle of light scattering that can monitor particle size and concentration changes in real-time. Through this technology, particle size information can be quickly obtained, which is suitable for real-time monitoring and control processes.
Data analysis and evaluation
We organize and analyze the obtained data, calculate the average size, size distribution, and other parameters of sludge particles, and generate reports or charts to display the analysis results. In addition, we will evaluate the impact of the size of sludge particles on the anaerobic digestion process according to the analysis results, and provide clients with professional suggestions to help them improve the process and optimize treatment efficiency.

Creative Biolabs has rich analysis and application experience, which can link the sludge granule size analysis results with the actual anaerobic digestion operation conditions to provide clients with targeted suggestions and improvement plans. If you need comprehensive sludge granule size analysis services, please contact us for specific matters and we will respond to your service needs promptly.
Published data
When studying the impact of anaerobic particle size on system performance in anaerobic biological wastewater treatment, the authors selected representative sludge granule samples and performed cleaning treatments. They then performed steps such as particle capture and image analysis. They first separated the particles that precipitated during the cleaning process and placed them in a Petri dish. Then they took images of the particles in the Petri dish and quickly and accurately measured the size distribution of the biological particles using a standard scanner and image analysis software. During the experiment, they also used high-quality ball-bearing spheres to calibrate and verify the analysis process. The results showed that this method was a reliable and easy-to-operate method for measuring biological particle size distribution.
 Fig.1 Particle diameter distribution measurement process.1, 2
Fig.1 Particle diameter distribution measurement process.1, 2
FAQs
Q1: Why is it necessary to analyze sludge granule size in anaerobic digestion?
A1: The size of sludge particles directly affects the adhesion and growth of microorganisms, and has an important impact on digestion efficiency, sedimentation performance, etc. By analyzing sludge granule size, the treatment process can be optimized, increasing efficiency and ensuring proper system operation.
Q2: How to interpret particle size analysis results?
A2: The analysis results will include information such as the average size and size distribution of the particles. Based on these data, we will evaluate the impact of the particles on the anaerobic digestion process and provide targeted suggestions, such as adjusting the stirring speed, controlling the particle size distribution, etc.
Q3: How to ensure the accuracy of sludge granule size analysis results?
A3: We adopt strict quality control measures, including repeated measurements, calibration of standard reference materials, etc., to ensure the reliability and accuracy of experimental results. Moreover, our team has rich experience and professional knowledge to ensure the accuracy and credibility of the data during the analysis process.
Customer Review
Excellent Particle Size Analysis Service Improves Client Production Efficiency
"Thank you to the Creative Biolabs team for providing us with excellent service! They not only provided accurate particle size data but also gave targeted improvement suggestions, which helped us improve our production efficiency."
Professional Sludge Particle Size Analysis Guides Clients' Anaerobic Digestion Process
"We are deeply impressed by the sludge granule size analysis service provided by Creative Biolabs! Their professional knowledge and technical equipment have given us a clearer understanding of the anaerobic digestion process, and they are trustworthy!"
References
-
Alves, Inaê, et al. "Determining the distribution of granule diameter from biological sludge." MethodsX 5 (2018): 727-736.
-
Under Open Access license CC BY 4.0, without modification.
For Research Use Only.
Related Services

Fig.1 Particle diameter distribution measurement process.1, 2
Fig.1 Particle diameter distribution measurement process.1, 2
